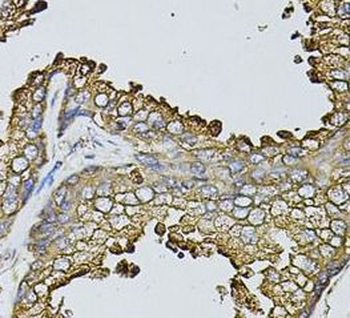
MYL1 Antibody

You have no items in your shopping cart.
You have no items in your shopping cart.
| Catalog Number | orb629086 |
|---|---|
| Category | Antibodies |
| Description | Rabbit polyclonal antibody to MYL1 |
| Target | MYL1 |
| Clonality | Polyclonal |
| Species/Host | Rabbit |
| Isotype | IgG |
| Conjugation | Unconjugated |
| Reactivity | Human, Mouse, Rat |
| Form/Appearance | liquid |
| Purity | ≥95% as determined by SDS-PAGE |
| Purification | Immunogen affinity purified |
| Immunogen | myosin, light chain 1, alkali; skeletal, fast |
| UniProt ID | P05976 |
| MW | 27 kDa |
| Tested applications | ELISA, IHC, WB |
| Dilution range | WB: 1:500 - 1:2000; IHC: 1:50 - 1:200 |
| Antibody Type | Primary Antibody |
| Storage | Maintain refrigerated at 2-8°C for up to 2 weeks. For long term storage store at -20°C in small aliquots to prevent freeze-thaw cycles. |
| Alternative names | MLC1F,MLC3F |
| Research Area | Epigenetics |
| Note | For research use only |

mouse heart tissue were subjected to SDS PAGE followed by western blot with orb629086 (MYL1 antibody) at dilution of 1:1000.
Immunohistochemistry of paraffin-embedded human human prostate using orb629086 (MYL1 antibody) at dilution of 1:100.
IF, IHC-Fr, IHC-P, WB | |
Mouse, Rat | |
Human, Mouse, Rat | |
Rabbit | |
Polyclonal | |
Unconjugated |
Human | |
0.16-10 ng/mL | |
0.057 ng/mL |
FC, IF, IHC-P, WB | |
Human, Mouse, Rat | |
Rabbit | |
Polyclonal | |
Unconjugated |
IHC-P, WB | |
Human, Mouse, Rat | |
Rabbit | |
Polyclonal | |
Unconjugated |
ELISA | |
Canine, Gallus, Human, Mouse, Porcine, Rat | |
Human | |
Rabbit | |
Polyclonal | |
Unconjugated |
Participating in our Biorbyt product reviews program enables you to support fellow scientists by sharing your firsthand experience with our products.
Login to Submit a Review